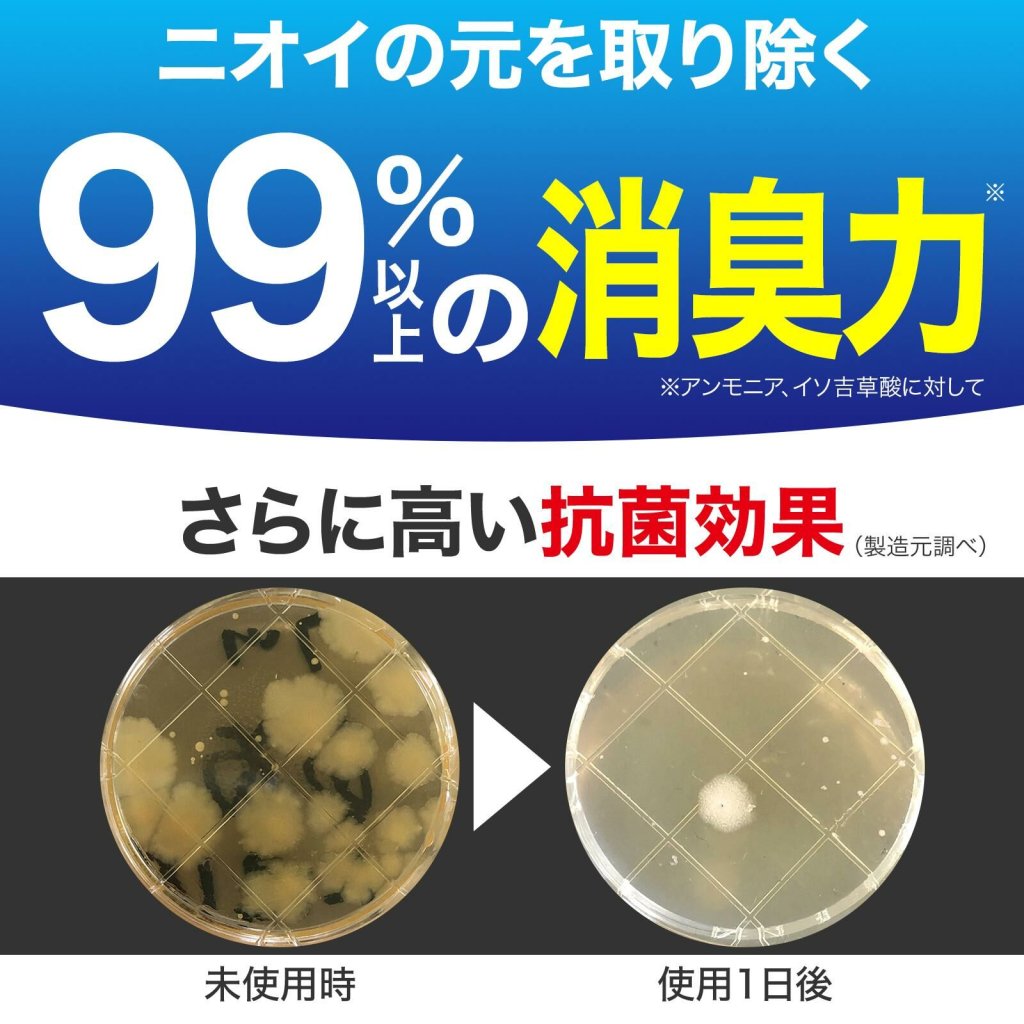

-
-
0My Cart{{item.promotion_name}}{{ presentmentCurrencyPriceFormat(item.total_price_with_addon)}} {{ presentmentCurrencyPriceFormat(item.price * item.qty)}}{{ presentmentCurrencyPriceFormat(item.net_price * item.qty)}} {{ presentmentCurrencyPriceFormat(item.price * item.qty)}}{{item.name}} ({{item.variant_name}})Qty: {{ item.qty }}Sub-total:{{ presentmentCurrencyPriceFormat(cart['subtotal']) }}You have no items in your cart !
Home
日本製 Clear Foot 消臭除菌鞋粉
{{product['name']}}
WEIGHT: {{selected_product['weight']}}KG
{{ isSelectedAllOptions ? presentmentCurrencyProductPriceRangeFormat(selected_product, 'original_price') : presentmentCurrencyProductPriceRangeFormat(product, 'original_price') }}
{{ isSelectedAllOptions ? presentmentCurrencyProductPriceRangeFormat(selected_product, 'price') : presentmentCurrencyProductPriceRangeFormat(product, 'price') }}
{{ps.product_series.display_name}}
{{ group.name }}
Required
{{ group.group_min_hints }}
{{ group.group_max_hints }}
{{ group.group_max_hints }}
Sales Begin at : {{dateFormat(product.schedule_sell.pss_start_date, 'YYYY-MM-DD HH:mm')}}
Sales End at : {{dateFormat(product.schedule_sell.pss_end_date, 'YYYY-MM-DD HH:mm')}}
{{product['negative_message']}}
{{product['negative_message']}}
Description
🎌日本製 Clear Foot 消臭除菌鞋粉🎌
鞋子著耐左,總會散發出一陣噁心難聞的味道😫
除左鞋之後,那令人反感的異味總是令人煩惱😭
如果旁邊有其他人,尷尬指數更是飆升!😣
一定要用呢款日本製除菌除臭鞋粉💥~~
高達99%的除臭效果🉐,能夠即刻擊退鞋子中的難聞氣味!
只需在散發異味的鞋子撒上它即可👍🏻~
🍀使用方法超簡單🍀
◆ 在鞋子內均勻灑上粉末(每隻鞋子約 2-3 次)。
◆ 輕輕搖晃鞋子,讓粉末均勻分佈。
◆ 穿上鞋子,然後繼續你的日常生活。
⚠ 注意事項:
◆ 適用於各種類型的鞋子。
◆ 使用後剛開始可能會看到粉末,但隨著時間的流逝,它會漸漸不再顯眼,讓你的鞋子保持清新如新👟
▪️尺寸|約12 x 4.7 x 3.2cm
▪️內容量| 50g
▪️成分|二氧化矽、明礬
📍產地:日本